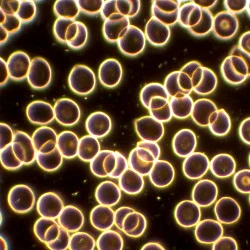
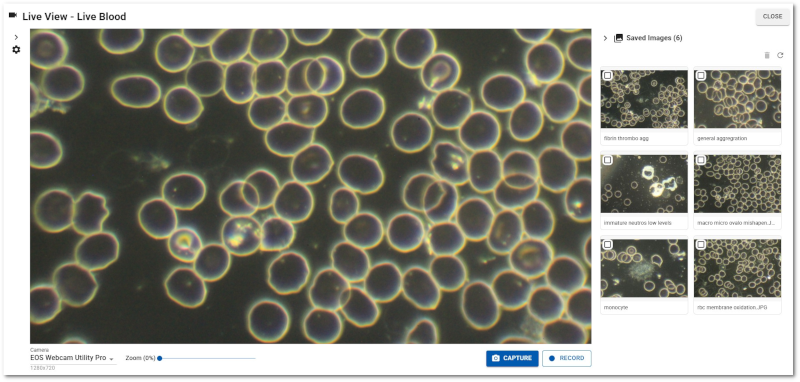
AnalystAssist Live Blood Analysis software

Buying a Microscope
for Live Blood Analysis
SAVE £250 off Training & Equipment, with our Turnkey LDBA Microscopy Package
Entering the world of microscopes for the first time can be daunting, however our courses will familiarise you with the necessary equipment, and teach you how to set up, use and care for your own microscope.
To help you choose the right microscope, we can take advantage of many years of experience using different microscopes for Live & Dry Blood Analysis.
We have identified several options below which we believe are excellent quality whilst offering great value for money, meaning we are happy to recommend these models to our students.
What do I need?
The Microscope
Microscopes are made up of a light source, a condenser that focuses and concentrates the light, a stage where the sample is mounted, objectives which contain the magnifying lenses, and a viewing head that includes eyepieces for viewing the sample, and a photo turret for connecting a camera.
Live Blood Analysis (the method that we teach) requires a specific type of microscope known as a 'dark-field' compound microscope. 'Dark-field' describes the way that the light is passed through the sample at an angle, highlighting the various elements within the blood that otherwise would be invisible under normal microscopy lighting.

In order to get the most detail possible, it is vital that the microscope has a powerful light source and high quality lenses with a high numerical aperture, allowing for a true representation of the blood sample.
Regarding light source, halogen lighting is the gold standard. Although less compact than L.E.D., the benefits in terms of luminescence, image quality and protecting your health far outweigh any disadvantages.
See this blog post “Advantages of halogen over L.E.D. illumination in darkfield microscopy” for more information.
Dark-field (sometimes called dark-ground) microscopy is a classic method for examining live blood. To see the necessary detail, live blood analysis requires a dark-field oil condenser and a x100 oil immersion objective (lens) with an inbuilt iris diaphragm.
Immersion oil is placed between the bottom of the microscope slide and the top of the condenser and also on top of the slide coverslip so that the front lens of the x100 objective goes into the oil (hence the name’ immersion’). It is essential that the immersion oil has the same refractive index(R.I.) as glass = 1.52. A word of caution - there are many sources of substandard immersion oil with the wrong R.I. that will affect the clarity of your image.
For dry blood analysis a 2.5x magnification objective is the best lens option and is used with a bright-field (non-oil) condenser. It is possible to also view live blood using a 40x objective with a bright field condenser, but the field of view is much larger than with 100x.
The numerical aperture (light gathering ability) of the objectives and condenser is equally important when using dark field, as blood cells will not reflect much of the light into the objective. The higher the value, the brighter and clearer the image - even small differences in this value equate to significant differences in the image quality and resolution (the detail you can see). Depending on the quality and manufacturing source of 100x objectives and dark field oil immersion condensers, their numerical aperture can range from 1.0 to 1.3.
The model chosen ideally includes a trinocular viewing head, meaning you can connect the device to a computer to store images, as well as viewing the sample normally using the binoculars. Eyepieces & photo tubes that give x10 magnification are preferred (giving the equivalent of 1000 times magnification with 100x objectives).
Caution: only the lens in the objective adds information. So brands declaring that their microscope’s 100x objective giving 1400 times magnification or more is better than one that gives 1000x magnification are being misleading. This is the same effect as a digital zoom - blowing up a smaller field of view within the sample BUT with less clarity.
Not all darkfield microscopes on the market will have these features, so it is important to choose carefully.
Red blood cells viewed under a 'dark field' microscope using a x100 objective (illustration purposes only)
Digital Imaging Equipment
Alongside your microscope you need a high definition imaging setup that enables you to display the magnified image digitally on a screen. This usually includes a digital USB camera (HD or 4K) that connects to the trinocular viewing head and specialist software for viewing and storing images.
This allows you to show the live image to your client, as well as capture stills of blood samples for your records.
Find out more about our new software platform for live blood analysis called AnalystAssist - click here.
Which Microscope Should I Buy?
Choosing which microscope to buy is a very important decision for new students, as you will hopefully be using the equipment for many years, and certain brands represent better image quality and longevity than others.
Although cheap microscopes claiming to be suitable for Live Blood Analysis are available, these invariably lack sufficiently powerful light sources and the required lens quality to produce detailed images at high magnification.
Budget LED microscope brands such as Amscope (read our review) and Omax are NOT usually suitable for professional Live Blood Analysis. In the past, students that have used these models have not been able to analyse the blood effectively or demonstrate to us their competency in doing so.
Conversely, there are also highly expensive models marketed for blood analysis, that are simply overkill when it comes to analysing blood effectively. There is no need to spend extortionate amounts of money on lots of features that you won’t need, when certain mid-range models (see below) give fantastic image quality and usability.
BUYER BEWARE!
We are aware of some unscrupulous training organisations online that sell their ‘own brand’ dark-field microscopes, and are making some misleading claims about the magnification and clarity of images that their microscopes can achieve (see above).
Don’t be persuaded by blood images or seller claims online - always check the power of the light source and the numerical aperture (NA) of supplied lenses to determine the image quality.
Microscopes are expensive pieces of scientific equipment - always buy an established optics brand and rely on specifications rather than images or claims about performance.

A student using the Brunel Haemascope
To help our students, we have arranged bespoke microscopy packages with several reputable microscope suppliers worldwide (see below).
All our recommended professional microscope packages are designed to be ideal for Live & Dry Blood Analysis, and represent excellent quality at great prices.
Please Note: We receive a sales commission on models purchased.
Brunel Haemascope 100W Dark-field
The highest specification microscopy package that we recommend, and the microscope that we use ourselves.
Featuring a 100W halogen light source, and lab quality lenses, this model offers excellent image and build quality, and is configured specially for blood analysis.
Available as equipment-only or:
Our ‘Turnkey LDBA Microscopy Package’ offers training, microscope and imaging equipment, and FREE international shipping - everything that you need to get started analysing blood samples!
Euromex iScope Dark-field

A very good microscope offering a high-quality image, compact design and great value for money.
We have fully tested this alternative to the Brunel Haemascope, and are happy to recommend it to our students for Live & Dry Blood Analysis.
Includes a unique lighting system using a LED light source embedded in the darkfield condenser, giving a much clearer image than budget models.